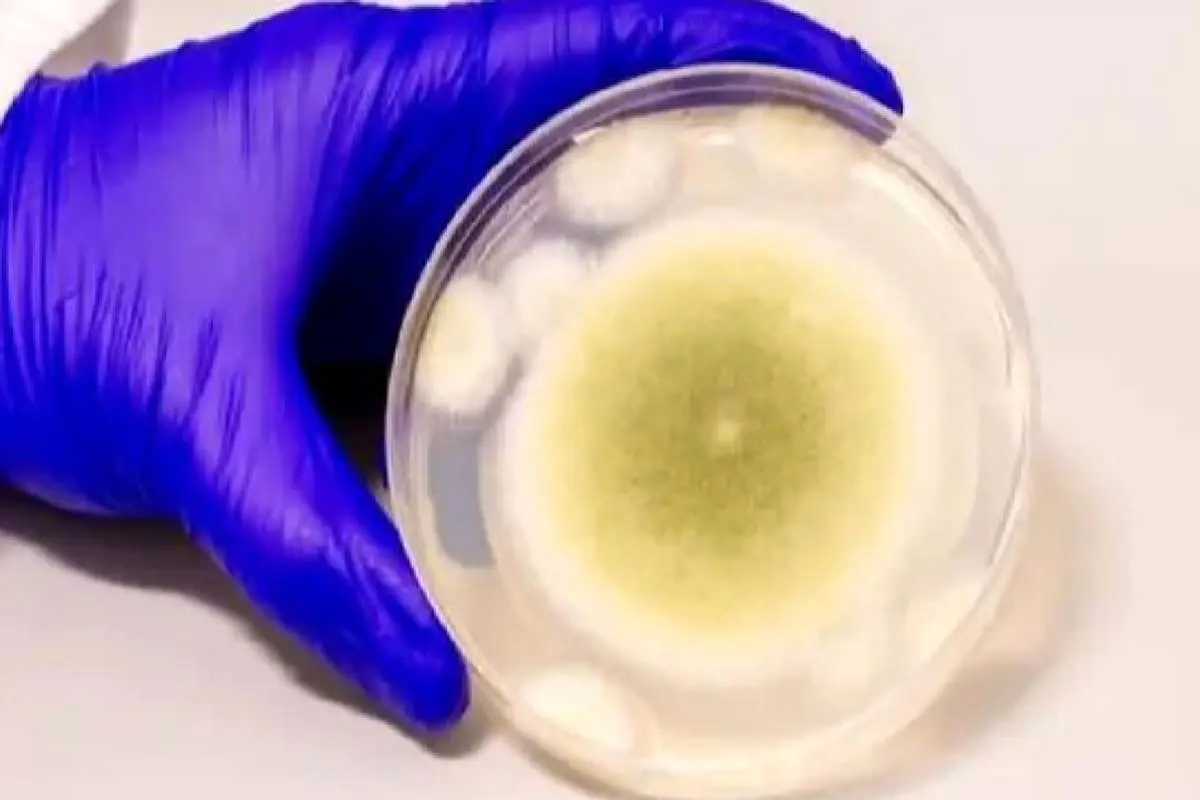
کشف داروی سرطان از قارچ مرگبار؛ ۱۰ دانشمند قربانی شدند

کشف داروی ضدسرطان در قارچی که باستانشناسان را کشت
از قارچ مرگباری که جان ۱۰ دانشمند را گرفته، اکنون دارویی قوی برای نابودی سرطان تولید شده است.
به گزارش شبکه اطلاع رسانی راه دانا؛ پژوهشگران موفق به استخراج دستهای جدید از مولکولها از قارچ مرگبار «Aspergillus flavus » شدهاند. آنها با استفاده از این قارچ کشنده به ترکیبی قدرتمند برای مبارزه با سرطان دست یافتهاند.
به گزارش از آیای، اهمیت این کشف زمانی دوچندان میشود که بدانیم این قارچ سمی که در محصولات کشاورزی یافت میشود، پیشتر با مرگهای مرموز در حفاریهای باستانشناسی مرتبط بوده است.
برای مثال، در سال ۱۹۲۲، پس از گشوده شدن مقبره توتعنخآمون(یکی از فراعنه مصر)، مرگهای عجیب و غیر قابل توضیحی رخ داد که شایعاتی درباره «نفرین فرعون» را به وجود آورد، اما بعدها این فرضیه مطرح شد که شاید یک قارچ عامل این مرگها بوده است.
در دهه ۱۹۷۰ نیز در لهستان، حادثهای مشابه رخ داد. ۱۰ دانشمند ظرف چند هفته پس از ورود به مقبره «کازیمیر چهارم» جان خود را از دست دادند. عامل این مرگها قارچی به نام «Aspergillus flavus » تشخیص داده شد، قارچی که به سمی بودن شدید معروف است.
اسپورهای زرد این قارچ، حتی پس از هزاران سال میتوانند عفونتهای شدید ریوی ایجاد کنند، بهویژه برای کسانی که سیستم ایمنی ضعیفی دارند.
اکنون همین میکروب کشنده، به منبعی غیرمنتظره برای کشف داروی ضدسرطان تبدیل شده است.
گروهی از پژوهشگران به رهبری پروفسور شری گائو(Sherry Gao) از دانشگاه پنسیلوانیا موفق به استخراج دستهای جدید از مولکولها از این قارچ شدهاند.
ارسال دیدگاه